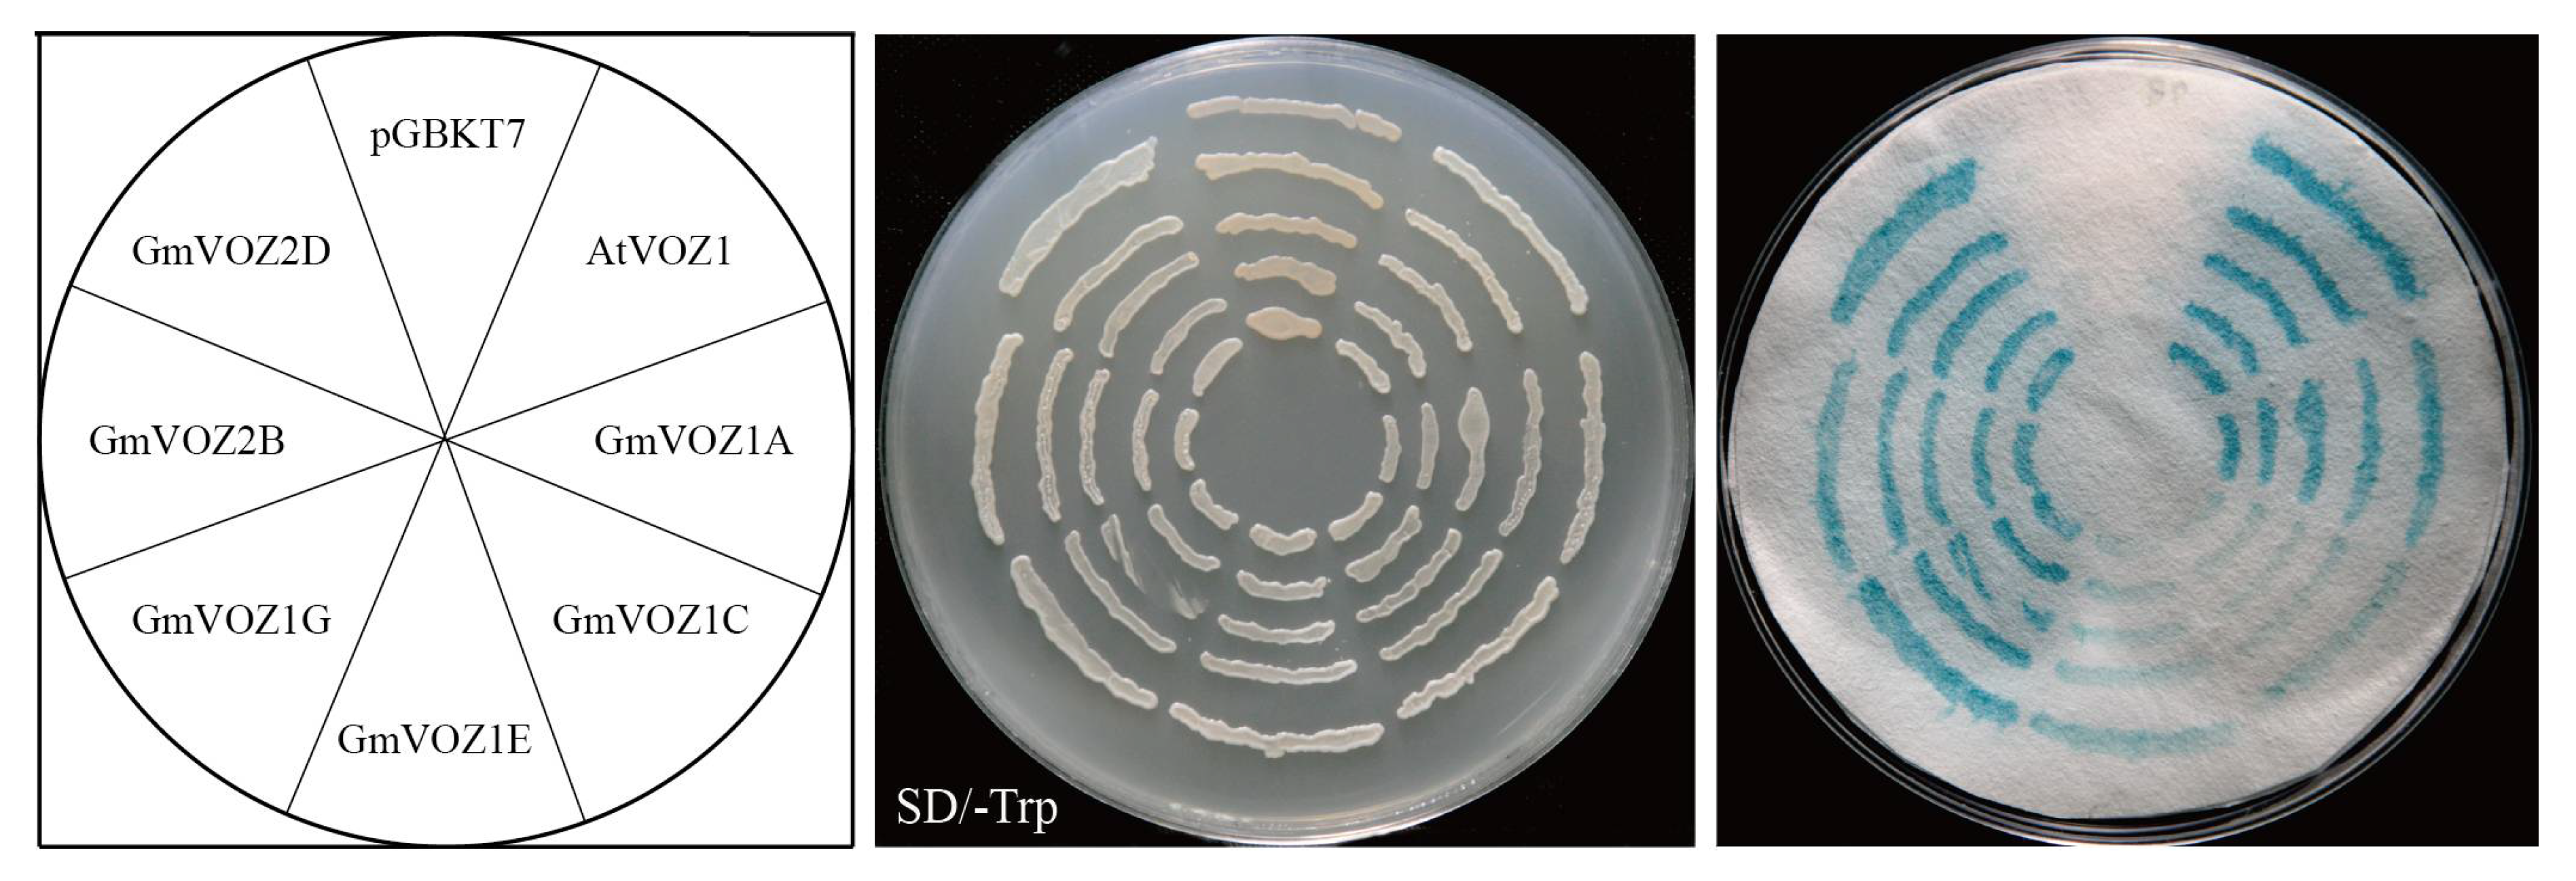
Ijms 21 02177 g004

Abstract
Vascular plant one-zinc-finger (VOZ) transcription factor, a plant specific one-zinc-finger-type transcriptional activator, is involved in regulating numerous biological processes such as floral induction and development, defense against pathogens, and response to multiple types of abiotic stress. Six VOZ transcription factor-encoding genes (GmVOZs) have been reported to exist in the soybean (Glycine max) genome. In spite of this, little information is currently available regarding GmVOZs. In this study, GmVOZs were cloned and characterized. GmVOZ genes encode proteins possessing transcriptional activation activity in yeast cells. GmVOZ1E, GmVOZ2B, and GmVOZ2D gene products were widely dispersed in the cytosol, while GmVOZ1G was primarily located in the nucleus. GmVOZs displayed a differential expression profile under dehydration, salt, and salicylic acid (SA) stress conditions. Among them, GmVOZ1G showed a significantly induced expression in response to all stress treatments. Overexpression of GmVOZ1G in soybean hairy roots resulted in a greater tolerance to drought and salt stress. In contrast, RNA interference (RNAi) soybean hairy roots suppressing GmVOZ1G were more sensitive to both of these stresses. Under drought treatment, soybean composite plants with an overexpression of hairy roots had higher relative water content (RWC). In response to drought and salt stress, lower malondialdehyde (MDA) accumulation and higher peroxidase (POD) and superoxide dismutase (SOD) activities were observed in soybean composite seedlings with an overexpression of hairy roots. The opposite results for each physiological parameter were obtained in RNAi lines. In conclusion, GmVOZ1G positively regulates drought and salt stress tolerance in soybean hairy roots. Our results will be valuable for the functional characterization of soybean VOZ transcription factors under abiotic stress.
1. Introduction
Plants grown in a natural environment are constantly affected by various environmental stimuli such as drought and salt stress. Upon exposure to these conditions, the expression of a wide spectrum of genes is induced, and their encoding products have been demonstrated to participate in molecular and cellular responses to diverse stresses [1,2,3,4,5,6,7,8]. Among these stress-induced genes, it should be pointed out that transcription factor genes regulate plant tolerance by activating or suppressing downstream target genes that are important for stress resistance. Thus, the transcriptional control of gene expression plays vital roles in plant responses to a range of stresses [9,10,11,12,13,14].
Vascular plant one zinc-finger proteins (VOZ) are a plant-specific transcription factor family with two members, VOZ1 and VOZ2, and exclusively exist in vascular plants and a moss, Physcomitrella patens [15]. VOZ transcription factors were initially identified as a kind of protein that specifically recognizes and binds to the GCGTNx7ACGC palindromic sequence in the regulatory region of the Arabidopsis V-PPase gene (AVP1) using yeast one-hybrid screening of a cDNA library [15]. Subsequently, the GCGTNx7ACGC palindromic sequence as a VOZ transcription factor binding site was reconfirmed, and several possible additional VOZ-binding cis-elements were also identified [16,17,18]. The examination of VOZ-binding cis-elements revealed that VOZ transcription factors might have pivotal roles in flowering. It has also been demonstrated that VOZ1/2 as phytochrome B-interacting transcription factors played redundant roles in regulating the transition from vegetative growth to flowering by up-regulating FLOWERING LOCUS T (FT) and down-regulating FLOWERING LOCUS C (FLC) expression in Arabidopsis [16,19]. On the other hand, VOZ1/2 has been shown to promoter flowering primarily by interacting with and modulating the function of CONSTANS (CO), whereas this is independent of FLC in Arabidopsis [17].
In addition to roles in flowering, it was documented that VOZ transcription factors as transcriptional regulators repress plant tolerance to abiotic stresses such as freezing, drought, and high temperature, but activate the resistance to biotic stresses including bacterial and fungal pathogens. For example, the overexpression of VOZ2 impaired transgenic plants freezing and drought stress tolerance but increased resistance to a fungal pathogen, Colletotrichum higginsianum, in Arabidopsis [20]. In Arabidopsis, voz1voz2 double mutants exhibited enhanced tolerance to freezing and drought stress but increased resistance to C. higginsianum and a bacterial pathogen, Pseudomonas syringae [21,22]. Recently, it was found that VOZ1 and VOZ2 mediated high-temperature stress response by independently suppressing the expression of DREB2C or DREB2A in Arabidopsis [23,24]. In contrast to freezing and drought stress, VOZ transcription factors play opposite roles in response to salt stress. As reported previously, VOZ1/2 could either directly or indirectly regulate the transcript level of a great number of stress-responsive genes, thereby conferring salt tolerance in Arabidopsis [18]. Moreover, the role of VOZ transcription factors in tolerance to iron-deficiency stress was also investigated in Arabidopsis, but the findings showed that VOZ1/2 did not play a significant physiological role in the iron-deficiency response [22].
Since the VOZ transcription factor was first reported [15], studies on its expression and functional validation were mainly concentrated on the model plant, Arabidopsis, but other species have rarely been investigated. Six VOZ transcription factors were demonstrated to exist in the soybean genome [25]. According to the Plant Transcriptional Regulatory Map (PlantRegMap) database [26], the VOZ transcription factor family has more members in soybean than in many other species, which suggests that soybean VOZ transcription factors may have more complex functions and participate in more regulatory mechanisms. Given the potential importance of VOZ transcription factors in growth, development, and the response to stress in soybean, we analyzed the sub-cellular localization and transcriptional activation activity of soybean VOZ family gene-encoded proteins, the expression profiles of GmVOZs in different soybean tissues and the response to dehydration, salt, and salicylic acid (SA) stress treatments. Moreover, the potential function of GmVOZ1G in the response of soybean to drought and salt stress was further investigated.
2. Results
2.1. Evolutionary and Phylogenetic Relationship of VOZ Proteins
Six soybean VOZ genes were annotated and designated as GmVOZ1A, GmVOZ1C, GmVOZ1E, GmVOZ1G, GmVOZ2B, and GmVOZ2D [25]. To elucidate the evolutionary history of soybean VOZ genes and their phylogenetic relationship with VOZ family genes in other organisms, VOZ proteins from five other plant species, Arabidopsis, rice, maize, foxtail millet, and P. patens, were aligned, and then a phylogenetic tree was constructed (Figure 1). All VOZ proteins were divided into three distinct clusters, denoted as cluster I to III. Cluster I contained soybean and Arabidopsis VOZ proteins. Cluster II had VOZ proteins from rice, maize, and foxtail millet, and P. patens VOZ proteins were assigned to cluster III. Multiple alignments showed that VOZ proteins from soybean, Arabidopsis, rice, and P. patens shared two conserved domains, termed domain-A and domain-B. Domain-B, containing a zinc finger motif composed of three conserved cysteines and one histidine residue, was also designated as the VOZ-domain (Figure S1) [15].
Figure 1.
Phylogenetic analyses of vascular plant one-zinc-finger (VOZ) proteins from soybean, Arabidopsis, rice, maize, foxtail millet, and P. patens. Each cluster (I, II, III) is highlighted in a different color.
2.2. Gene Structure and Cis-Acting Elements
As an evolutionary relic, the exon–intron organization might provide useful information for the evolution of a gene family. As shown in Figure 2a, all GmVOZ genes, interrupted by three introns, displayed similar exon–intron boundaries. To determine cis–acting elements in the promoter region of GmVOZ genes, an analysis of cis–acting elements was performed in the database PlantCARE. The results showed that GmVOZ genes carried abundant stress-related cis–acting elements in their promoters, such as ABRE, G–Box, LTR, MYB, MYC, MBS, TCA–element, CGTCA–motif, W-box or TC-rich repeats, and the numbers varied from one to five. Additionally, two or more light-related cis–regulatory Box4 elements were searched in the promoters of GmVOZ1A, GmVOZ1C, GmVOZ1E, and GmVOZ1G (Figure 2b). The analysis of cis–elements in the promoter of GmVOZ genes contributed to predicting their biological functions.
Figure 2.
Analysis of exon/intron structures and cis–acting elements. (a). Exon/intron structures of soybean VOZ genes were created with GSDS. Lengths of introns and exons are shown proportionally. (b). Putative cis-acting elements in a 2.0 kb 5’ flanking region upstream from the start codon of VOZ genes in soybean.
2.3. Subcellular Localization of GmVOZ Proteins
The subcellular localization of a protein is closely related to its biological function [27]. To investigate the subcellular distribution of GmVOZ proteins, the open reading frames (ORFs) of GmVOZ genes, lacking the stop codon, were fused to the N-terminal end of the GFP reporter gene. The recombinant GmVOZs–GFP fused plasmids were transformed into Arabidopsis protoplasts and monitored by confocal microscopy. It was observed that GmVOZ1E, GmVOZ2B, and GmVOZ2D were located primarily in the cytosol, and the GFP fluorescence of GmVOZ1G fusion protein mainly appeared in the nucleus. GmVOZ1C was probably located in the nucleus, and the possibility of localization in other organelles, such as endoplasmic reticulum (RE), mitochondria or chloroplasts, could also not be ruled out. This is uncertain due to the lack of the corresponding control (Figure 3). Additionally, the fluorescence of GmVOZ1A fusion protein was not detected in Arabidopsis protoplasts cells (Figure 3).
Figure 3.
Subcellular localization of soybean VOZ proteins. The recombinant plasmids of GmVOZs–GFP were transformed into Arabidopsis protoplasts. Results were visualized with confocal microscopy 18 h after transformation. Scale bars = 10 μm.
2.4. Transcriptional Activation Activity Analysis of GmVOZ Proteins
The transcriptional activation activity of GmVOZ proteins was analyzed using a yeast transactivation system. GmVOZ genes were subcloned into a yeast GAL4-DNA binding domain expression vector (pGBKT7), which was subsequently transformed into yeast strain AH109, and then the ability of GmVOZ proteins to activate the transcription of the LacZ reporter gene was detected. As shown in Figure 4, the yeast strain cells harboring the different recombinant plasmids grew well on selective medium SD/-Trp. When we used X–α–Gal, it was discovered that the positive control pGBKT7-AtVOZ1 and the cells containing pGBKT7-GmVOZs showed β–galactosidase activity, whereas the negative control pGBKT7 had no β–galactosidase activity, indicating that soybean VOZ proteins possessed transcriptional activation activity in yeast cells. This finding is in accordance with a previous report on the transactivation activity of VOZ proteins in Arabidopsis [15]. Moreover, GmVOZ1C and GmVOZ1E displayed relatively lower levels of transcriptional activation activity, as determined by their ability to activate the expression of the LacZ reporter gene (Figure 4).
Figure 4.
Transcriptional activation activity of soybean VOZ proteins in yeast cells. pGBKT7 and pGBKT7-AtVOZ1 were used as negative and positive controls, respectively.
2.5. Expression Pattern of VOZ Genes in Different Soybean Tissues
A RNA–Seq atlas of Glycine max was used to identify the expression pattern of GmVOZ genes in different tissues [28]. Fourteen tissues at different stages were selected for analysis, including a young leaf, flower, root, nodule, and various stages of pod and seed development. GmVOZ genes were expressed in nearly all tissues tested, while the basal expression of GmVOZ1A was not detected in the RNA–Seq atlas (Figure 5). The results revealed that distinct GmVOZ genes exhibited high variation in their expression profiles, dependent on tissue/organ types and developmental stages. GmVOZ2D had higher expression levels in the young leaf, pod, and root, while GmVOZ1E had no expression in the young leaf or seed at 10 DAF (days after flowering) but was highly expressed in the root. GmVOZ1C was expressed most strongly in the flower. GmVOZ2B transcription was most enriched in the nodule. GmVOZ1G showed higher expression level in the root but no expression in 10-, 14-, 25-, 28-, and 42-DAF seed (Figure 5). The above results show that VOZ transcription factors may play diverse roles in the growth and developmental regulation of soybean.
Figure 5.
Expression analysis of soybean VOZ genes at different developmental stages in specific organs. Data was extracted from the SoyBase database [28].
2.6. Expression Profiles of GmVOZ Genes in Responses to Abiotic and SA Stress
To explore the possible involvement of individual GmVOZ genes in response to abiotic and biotic stress, the expression patterns of GmVOZ genes were initially detected by quantitative real-time PCR (qRT–PCR) in leaves under dehydration, high salinity, and SA stress treatments. Expression data showed that four GmVOZ genes had obviously different transcriptional responses to dehydration. Among these genes, the transcription levels of GmVOZ1A and GmVOZ1G were significantly upregulated and reached a maximum at 3 h (5.2-fold) and 24 h (13.9-fold), respectively. Conversely, GmVOZ1C and GmVOZ1E were significantly downregulated post treatment. GmVOZ2B and GmVOZ2D showed a slight response to dehydration stress (increased <3.0-fold). All GmVOZ genes were involved in high salinity stress responses (Figure 6a). Similar to dehydration stress treatment, the expression levels of GmVOZ1A and GmVOZ1G were significantly upregulated after high salinity treatment, and the highest transcription levels occurred at 12 h and 24 h, which were equivalent to 5.8-fold and 13.3-fold increases, respectively. The expression of GmVOZ1C showed a significant decrease post high-salinity treatment. Although they participated in the salt stress response, the expressions of GmVOZ1E, GmVOZ2B, and GmVOZ2D showed weak changes (increased <3.0-fold or 2.0-fold) (Figure 6b). Following SA stress treatment, GmVOZ1A, GmVOZ1C, and GmVOZ1E were significantly downregulated, especially GmVOZ1E; GmVOZ2B and GmVOZ2D were initially down-regulated at 1-6 h, then began to be significantly up-regulated at 9 h after treatment was initiated, and reached a peak at 24 h (14.2-fold) and 12 h (7.2-fold), respectively. In terms of GmVOZ1G, the expression level was increased >4.0-fold after treatment (Figure 6c). These observations suggest that soybean VOZ transcription factors may play diverse roles in plant responses to abiotic and biotic stresses.
Figure 6.
Expression profiles of soybean VOZ genes under dehydration, salt, and salicylic acid (SA) treatments. Quantitative real-time PCR (qRT-PCR) analysis of VOZ genes in soybean seedlings in response to dehydration (a), NaCl (b), and SA (c). The relative transcription levels of GmVOZ genes were normalized to the expression of tubulin. The data are presented as means ± SD of four biological replicates. The asterisks indicate statistical differences in comparison with the corresponding controls at p < 0.01 (**) and 0.01 < P < 0.05 (*), respectively.
2.7. GmVOZ1G Positively Regulates Drought and Salt Stress Tolerance in Soybean Hairy Roots
In view of the significance of the response to dehydration and high salinity stress treatments, we hypothesized that GmVOZ1G might play an important role in regulation during drought and salt stress responses. Thus, the role of GmVOZ1G in drought and salt-stress tolerance was examined by conducting corresponding stress assays in Agrobacterium rhizogenes–mediated transformation of soybean hairy roots [29]. The transformation efficiency of hairy roots was estimated by histochemical GUS staining. As shown in Figure 7a, the ratio of positive hairy roots was relatively high (>60%) in each soybean composite plant. qRT–PCR analysis showed a higher accumulation of GmVOZ1G transcription in hairy roots overexpressing GmVOZ1G and a lower expression level in RNAi hairy roots compared with the empty vector (EV) control (Figure 7b). After using the above transformation method, a soybean composite plant consisting of a wild-type shoot with transgenic hairy roots is generated [29]. The expression of GmVOZ1G was also detected by qRT–PCR in leaves and shoot of soybean composite plants. The results showed that the expression of GmVOZ1G had no obvious changes in leaves/shoot of soybean composite plants with overexpression or RNAi hairy roots compared with the EV control (data not shown).
Figure 7.
Assessment of the effect of drought and salt stress on GmVOZ1G transgenic soybean hairy roots. (a). GUS detection of the transformation efficiency in soybean hairy roots. (b). qTR–PCR analysis of GmVOZ1G transcription levels in overexpression of GmVOZ1G, RNAi, and empty vector (EV) control soybean hairy roots. The expression level of tubulin was used as a quantitative control. The means of four biological replicates and the standard deviation are presented. (c). Soil water potential (SWP) was determined under normal and drought stress conditions. (d). Phenotypes of soybean composite seedlings with overexpression, RNAi, and EV control hairy roots under drought and salt stress treatments. (e−h). Relative water content (RWC), malondialdehyde (MDA) content, peroxidase (POD), and superoxide dismutase (SOD) activities in leaves of soybean composite seedlings with different transgenic hairy roots under normal and stress conditions. All values are the means and SD of three independent replicates. The asterisks indicate statistical differences in comparison with the corresponding controls at p < 0.01 (**) and 0.01 < p< 0.05 (*), respectively.
In order to test whether GmVOZ1G overexpression or inhibition could change the response of hairy roots to abiotic stress, the drought and salt tolerances of soybean composite plants with transgenic hairy roots were examined. After 12 days of withholding watering, the obvious phenotypic differences were observed among different composite soybean lines. Meanwhile, soil water potential (SWP) was determined. As shown in Figure 7c, SWP had no significant difference among different composite soybean lines under control and stress conditions, and SWP was reduced to approximately –1500 kPa under water deficit condition, this indicates that plants were subjected to severe drought stress [30]. In the absence of stress, there were no apparent differences in shoots among composite seedlings with RNAi, EV control, and the overexpression of hairy roots. Although leaves from composite seedlings were curled, bleached, and withered after 12 days of drought treatment, composite seedlings carrying the RNAi hairy roots were the most severely damaged, followed by the EV-control hairy roots; the least severely damaged were the overexpressed hairy roots. After being re-watered and grown under normal conditions for three days, the majority of leaves from composite seedlings with an overexpression of hairy roots returned to being green, whereas few composite seedlings with RNAi hairy roots were able to do this. Compared with the EV control lines, composite seedlings carrying RNAi hairy roots were more sensitive to salt stress, while overexpressed hairy roots were not. The leaves from composite seedlings with RNAi hairy roots wilted under salt stress for 12 days, and leaves gradually yellowed in composite seedlings with EV-control hairy roots, whereas leaves remained green in composite seedlings with overexpressed hairy roots (Figure 7d). Relative water content (RWC) in plants determines sensitivity to water stress [31]. It was observed that RWC in leaves of soybean composite plants with RNAi hairy roots was significantly lower, and markedly higher in overexpression lines than in the EV-control lines after eight days of drought treatment (Figure 7e).
Malondialdehyde (MDA), superoxide dismutase (SOD), and peroxidase (POD) are important indicators reflecting cell oxidative damage [32]. To explore the potential physiological mechanisms of GmVOZ1G overexpression or RNAi hairy roots in enhancing or decreasing drought and salt tolerance, changes in the MDA content and SOD and POD activities in leaves of soybean composite seedlings carrying RNAi, the EV control, and overexpressed hairy roots with or without stress treatments were investigated. No significant differences in the MDA content and SOD and POD activities were observed in RNAi, the EV control, and overexpression lines under non-stress conditions. Under drought and salt stress for eight days, the MDA content and SOD and POD activities increased in all RNAi, EV-control, and overexpression lines. Compared with the EV control, the MDA content displayed a significantly higher accumulation in RNAi lines, but an obviously lower accumulation was observed in overexpression lines. However, the activities of SOD and POD were dramatically lower in RNAi lines, and markedly higher in overexpression lines (Figure 7f–h). Taken together, these findings demonstrate that GmVOZ1G is a positive regulator of plant tolerance to drought and salt stress.
3. Discussion
Although VOZ genes have been previously classified as members of the VIII-2 subfamily of the NAC transcription factor family, the sequence alignments showed a low homology at the NAC domain between VOZ and NAC proteins in Arabidopsis [33]. Moreover, NAC and VOZ proteins are divided into two separate transcription factor families in the PlantRegMap database [26]. Recently, an evolutionary analysis also agreed with the classification of VOZ genes as an independent gene family [25]. Compared to soybean, the VOZ gene family is relatively small, with two members in the Arabidopsis, foxtail millet, rice, Brachypodium distachyon or tobacco genome [15,25]. These data indicate that the number of VOZ family genes in soybean has expanded compared with other species as mentioned above; this might be due to two genome duplication events in soybean [34]. Soybean VOZ proteins could be clustered together with VOZ proteins from dicotyledonous Arabidopsis, but not with VOZ proteins from monocotyledonous rice, maize, and foxtail millet in the same clade, this demonstrates that VOZ transcription factors have diverged before monocot and dicot plants differentiated. Intron gain or loss is one of the evolutionary mechanisms underlying the genesis of a gene family [35,36,37]. The exon/intron structure analysis revealed that dicotyledonous soybean and Arabidopsis VOZ genes shared an analogous intron distribution pattern that was different from that in monocotyledonous rice and foxtail millet (Figure 2a and Figure S2), implying that the diverse status of exon and intron splicing might play a significant role in the evolutionary process of VOZ genes between monocots and dicots.
Although VOZ transcription factors were assumed to function as transcriptional activators [15], VOZ1/2 proteins were dispersed primarily in the cytosol under normal growth conditions [19,22]. Recently, it was reported that VOZ proteins relocated to the nucleus, and subsequently were rapidly degraded via the ubiquitin/26S proteasome system under certain stress conditions [22,24]. Moreover, VOZ proteins translocated from the cytoplasm to the nucleus and participated in the regulation of flowering signaling in Arabidopsis [19], suggesting that the nuclear localization of VOZ transcription factors is required for their functions. Interestingly, GmVOZ1G was predominantly located in the nucleus under non-stress conditions (Figure 3), indicating that GmVOZ1G might play different regulatory roles in plant growth, development or stress responses compared with VOZ transcription factors located in the cytosol. To a certain extent, this was confirmed by the fact that GmVOZ1G acted as a positive regulator in drought stress tolerance (Figure 7). In Arabidopsis, VOZ1/2 negatively regulated drought, cold, and high-temperature stress tolerance through the 26S proteasome–mediated degradation of VOZ proteins in the nucleus [21,22]. Experimental evidence is required to confirm whether GmVOZ1G is degraded by the ubiquitin/26S proteasome under non-stress or stress conditions.
The roles of the phytohormones abscisic acid (ABA), SA, and ethylene (ET) in the adaptation of plants to various abiotic stresses and pathogenic infection have been well characterized [38,39,40,41,42,43,44,45]. VOZ1/2 were also shown to participate in regulating SA- and jasmonic acid (JA)-mediated defense responses to pathogens in Arabidopsis [21]. In the current study, our data revealed that individual GmVOZ genes possessed at least one ABA-responsive element (ABRE), SA-responsive element (TCA–element) or ET-responsive element (ERE) in their promoter regions (Figure 2b and Table S2). In addition, several stress-related cis-acting elements were also identified in the promoter region of GmVOZ genes (Figure 2b and Table S2), with evidence demonstrating that these cis-elements are involved in responses to drought, salt, low temperature or pathogen attack [46,47,48,49,50,51]. In light of the existence of these cis-acting elements, GmVOZ genes are proposed to play a broad role in plant responses to abiotic and biotic stresses. This was further supported by the observation that GmVOZ genes were involved in the response to dehydration, salt, and SA stress treatments (Figure 6).
It was proposed that abiotic and biotic stresses mediate the expression of overlapping sets of genes in plants [52]. Our expression data showed that GmVOZ1G was significantly upregulated by dehydration, salt, and SA stress treatments, whereas GmVOZ1C was downregulated. Other GmVOZ genes displayed diverse response mechanisms under different stress treatments (Figure 6). Interestingly, GmVOZ1 genes showed a significant alteration in the expression levels in response to dehydration and salt stress treatments, and the transcript levels of GmVOZ2 genes showed a weak change. In response to SA stress treatment, the expression levels of GmVOZ1 genes were significantly decreased, except for GmVOZ1G, whereas GmVOZ2 genes were obviously upregulated (Figure 6). These observations suggest that GmVOZ2 transcription factors might be involved specifically in the response to biotic stress, and GmVOZ1 and GmVOZ2 transcription factors likely play diverse roles in biotic stress responses. More work is needed to investigate the specific function of soybean VOZ transcription factors in response to abiotic and biotic stresses.
VOZ transcription factors were isolated as proteins that bind to a special cis-acting region responsible for the pollen-specific gene expression of AVP1 [15,53]. In Arabidopsis, VOZ1/2 have also been shown to play essential roles in regulating flowering time [16,17,19]. Here, valuable information was provided on the conserved functional roles of VOZ genes by phylogenetic data and multiple sequence alignments of VOZ proteins from soybean and other species [Figure 1, Figure S1]. Thus, it is possible that soybean VOZ transcription factors participate in flowering regulation. Light, as a key environmental factor, affects flowering time [54]. In the present study, the cis-acting element analyses showed that GmVOZ1 genes contained two or more light-related cis-elements of Box4 in their promoter regions [55]. Additionally, the expression patterns in different soybean tissues showed that GmVOZ1C transcription was most enriched in flowers. These observations indicate that GmVOZ1 transcription factors might be required for the regulation of flowering. Nevertheless, no evidence was provided here to determine whether GmVOZ2 transcription factors are involved in flowering time control. More experimental evidence is needed to uncover the role of soybean VOZ transcription factors in regulating flowering.
4. Materials and Methods
4.1. Sequence Alignment and Phylogenetic Analysis
The peptide sequences of the VOZ protein from different species were obtained from the Phytozome (version 12.1) database. The ClustalX (version 2.1) program was used to perform multiple sequence alignments of the VOZ family protein [56]. The phylogeny was obtained by the neighbor-joining method using MEGA6.0 software with the following parameters: 1000 bootstrap replicates [57].
4.2. Gene Structure and Potential Cis–Acting Element Analysis
The coding and genomic DNA sequences of the soybean VOZ gene were retrieved from the Phytozome database. The exon–intron arrangements of soybean VOZ genes were defined using the online program Gene Structure Display Server2.0 (GSDS) by comparing coding sequences and the corresponding genomic DNA sequences [58]. The 2.0 kb promoter sequences upstream of the soybean VOZ gene transcription initiation site were extracted from the Phytozome database. Potential cis-acting elements of extracted promoter regions were analyzed using the PlantCARE database [59].
4.3. Sub-cellular Localization and Transcriptional Activation Analysis
The coding regions of the soybean VOZ gene were amplified and subcloned into the 16318GFP expression vector using the BamHI restriction site. The reconstructed VOZs–GFP fused plasmids were transferred into Arabidopsis protoplasts using the PEG4000-mediated transformation method, and the empty 16318GFP vector was used as the control. The GFP signal was detected by a laser scanning confocal microscopy (Zeiss LSM 700, Germany) after incubating in darkness at 22 °C for 18 h [60].
The full-length cDNA sequences of the soybean VOZ gene and Arabidopsis VOZ1 were individually amplified and fused into the pGBKT7 vector using the EcoRI restriction site to assess protein transcriptional activity in yeast cells. pGBKT7-AtVOZ1 and pGBKT7 were used as the positive and negative control, respectively. The reconstructed plasmids were transformed into yeast host strain AH109 using YeastmakerTM Yeast Transformation System 2 kit (Clontech, USA) according to the manufacture’s protocol. Transcriptional activity was analyzed according to the methods established in prior work [61]. Yeast cells harboring the reconstructed plasmids were cultivated on selective media SD/-Trp [0.67% (m/v) yeast nitrogen base, 2% (m/v) glucose, and 0.074% (m/v) -Trp DO Supplement (Clontech, USA), pH 5.8−6.0] for three days at 30 °C. Yeast strain grown on selective media SD/-Trp were transferred to filter paper and frozen with liquid nitrogen, and subsequently incubated with a Buffer/X–α–Gal solution [0.59 mM Na2HPO4·7H2O, 0.35 mM NaH2PO4·H2O, 0.098 mM KCl, 0.33% (v/v) β–mercaptoethanol, and 0.34 mg mL−1 X–α–Gal] for 8 h at 30 °C. The primers are listed in Supplementary Table S1.
4.4. Expression Patterns of GmVOZ Genes in Different Tissues
The expression analysis of soybean VOZ genes in different tissues and development stages was conducted using gene transcript abundance values obtained from the SoyBase database [28]. The heatmap was produced by TBtools software [62].
4.5. Plant Materials and Stress Treatments
Soybean variety Williams 82 and Arabidopsis plants of the Col-0 ecotype were used throughout this study. Soybean seedlings were grown in pots containing a mixture of humus and vermiculite (1:2, v/v) in a greenhouse at 26 °C with a 16-h-light/8-h-dark photoperiod and 60% relative humidity. Arabidopsis plants were grown in mixed soil (humus:vermiculite = 1:1) in a growth chamber under a 16-h-light/8-h-dark photoperiod at temperature of 24 °C. Fifteen-day-old soybean seedlings were exposed to different stress treatments. Stress treatments were performed as follows: for dehydration, soybean seedlings were removed from the soil and then placed on filter paper under 60% relative humidity at room temperature (22 °C). For salt treatment, the roots of seedlings were subjected to 200 mM NaCl solution. SA stress treatment was performed as described previously [63]. The leaves under different treatments were sampled for RNA extraction at 0, 1, 3, 6, 9, 12, and 24 h.
4.6. RNA Extraction and Quantitative Real-time PCR (qRT–PCR)
Total RNA was extracted from plant samples using Trizol solution (TaKaRa, Japan), and first-strand cDNA was reverse-transcribed using the PrimeScript 1st Strand cDNA Synthesis Kit (TaKaRa, Japan). qRT–PCR analysis was conducted with an ABI prism 7500 Real-Time PCR system (Applied Biosystem, Life Technologies, Carlsbad, CA, USA) using Top Green qPCR SuperMix (+ Dye I) kit (TransGen, Beijing, China). PCR was performed after a preincubation at 94 °C for 30 s and was followed by 40 cycles of amplification (94 °C for 5 s, 58 °C for 15 s, and 72 °C for 32 s). Each sample with four biological replicates was quantified using the 2−ΔΔCt method according to the cycle threshold (Ct) values [64]. The transcript level of the soybean tubulin gene (Glyma.03g124400) was used as an internal control. All primer sequences were designed using Primer Premier 5.0 software and are detailed in Table S1.
4.7. Agrobacterium Rhizogenes–Mediated Transformation of Soybean Hairy Roots
For the overexpression vector construction, the coding sequence of GmVOZ1G was amplified and cloned into the pCAMBIA3301 expression vector using the NcoI and BstEII restriction sites, resulting in the construct pCAMBIA3301-GmVOZ1G. In order to generate the RNAi suppression vector pCAMBIA3301-GmVOZ1G-RNAi, a 666 bp ligated sequence, containing a GmVOZ1G fragment (from positions -23 to 227) and its antisense fragment, with a fragment of intron 1 of maize alcohol dehydrogenase-1 (Adh1) between the two GmVOZ1G fragments, was synthesized (Biomed, Beijing, China) and inserted into the pCAMBIA3301 vector using the NcoI and BstEII restriction sites. The primers and sequence used in this assay are listed in Table S1. The constructs were transformed into hairy roots using a high-efficiency A. rhizogenes-mediated genetic transformation method established in prior work [29]. Seven-day-old seedlings with unfolded cotyledons were injected with A. rhizogenes strain K599 harboring the reconstructed plasmids at the cotyledonary node. Subsequently, the infected seedlings were transferred into vermiculite and kept in a high humidity and temperature condition. When hairy roots generated at the infection site and could support the plants (approximately 5–10 cm in length), the primary roots were removed and the transgenic hairy roots were tested by qRT–PCR. Soybean composite seedlings consisting of transgenic hairy roots were transplanted into nutritious soil (humus:vermiculite = 1:2) and cultured in 16-h-light/8-h-dark photoperiod at 28 °C in a greenhouse. Finally, 119 (OE), 132 (RNAi), and 165 (EV control) soybean composite plants with similar growth patterns and expression level of GmVOZ1G in hairy roots were selected for further study, respectively.
For drought treatment, water was withheld from two-week-old soil-grown soybean composite seedlings for 12 days, after which they were re-watered and allowed to recover for three days. For salt treatment, two-week-old soil-grown soybean composite seedlings were subjected to treatment with 200 mM NaCl solution for 12 days. The content of MDA, SOD, and POD activities in leaves were measured eight days after drought and salt treatments with the corresponding test kits (Cominbio, Suzhou, China) according to the manufacture’s protocols. All experiments were repeated independently at least three biological replicates.
4.8. GUS Staining
For GUS histochemical staining assay, the transgenic hairy roots (EV control) were incubated with a GUS staining solution [1 mg mL−1 5-bromo-4-chloro-3-indolyl β–D–glucuronic acid, 1.0 mM K3Fe(CN)6, 1.0 mM K4Fe(CN)6, 50 mM Na2HPO4 buffer, pH 7.0, 10 mM EDTA, and 0.1% (v/v) TritonX-100] (Real Times, Beijing, China) for 16 h at 37 °C, followed by treating with 70% ethanol for 8 h.
4.9. Measurement of Soil Water Potential (SWP) and Relative Water Content (RWC)
SWP was measured using WP4-T Dewpoint meter (Decagon Devices, Pullman, WA, USA) according to the manufacturer’s instructions [30]. RWC was determined in leaves of soybean composite plants as described previously [30,65].
4.10. Statistical Analysis
A Student’s t test analysis was performed in Microsoft Excel 2007. Data are shown as means ± standard deviation (SD), with a P-value cut-off of 0.05.
5. Conclusions
An extensive investigation of six soybean VOZ genes was conducted in terms of their phylogeny, sequence, expression analyses, and responses to abiotic stress. The observations demonstrate that soybean VOZ genes act as important components of stress response and have complex regulatory mechanisms in plants. Our study provides valuable information for a more detailed analysis of the biological function of VOZ genes in soybean.
Supplementary Materials
Supplementary materials can be found at https://www.mdpi.com/1422-0067/21/6/2177/s1. Figure S1. Alignments of VOZ proteins from soybean, Arabidopsis, rice, and P. patens. Black lines indicate two conserved domains. Red boxes indicate conserved residues possibly forming functional zinc-coordinating motifs. Figure S2. Intron/exon structures of VOZ genes in Arabidopsis, rice, and foxtail millet. Table S1. The primers and sequences used in this study. Table S2. Cis–acting elements in the promoters of soybean VOZ genes.
Author Contributions
Y.-Z.M. conceived and directed the project; Z.-S.X. designed the experiments; B.L. performed experiments and wrote the first draft; J.-C.Z. and T.-T.W. conducted the bioinformatic work and performed experiments; D.-H.M., W.-L.W., J.C., Y.-B.Z., and M.C. read and commented on the manuscript. All authors have read and approved the final manuscript.
Funding
This research was financially supported by the National Natural Science Foundation of China (31871624) and the National Transgenic Key Project of the Chinese Ministry of Agriculture (2018ZX0800909B and 2016ZX08002-002).
Acknowledgments
We are grateful to. Lijuan Qiu of the Institute of Crop Science, Chinese Academy of Agricultural Sciences for kindly providing soybean seeds.
Conflicts of Interest
The authors declare that they have no competing interest.
Abbreviations
| VOZ | Vascular plant One-Zinc finger |
| MDA | Malondialdehyde |
| POD | Peroxidase |
| SOD | Superoxide dismutase |
| qRT–PCR | Quantitative real-time PCR |
| GFP | Green fluorescent protein |
| SA | Salicylic acid |
| ORF | Open reading frame |
| FW | Fresh weight |
| EV | Empty vector |
References
- Zhu, J.K. Plant salt tolerance. Trends Plant Sci. 2001, 6, 66–71. [Google Scholar] [CrossRef]
- Zhu, J.K. Abiotic Stress Signaling and Responses in Plants. Cell 2016, 167, 313–324. [Google Scholar] [CrossRef]
- Xiong, L.M.; Schumaker, K.S.; Zhu, J.K. Cell signaling during cold, drought, and salt stress. Plant Cell 2002, 14, S165–S183. [Google Scholar] [CrossRef]
- Yang, Y.; Guo, Y. Elucidating the molecular mechanisms mediating plant salt-stress responses. New Phytol. 2018, 217, 523–539. [Google Scholar] [CrossRef]
- Deinlein, U.; Stephan, A.B.; Horie, T.; Luo, W.; Schroeder, J.I. Plant salt-tolerance mechanisms. Trends Plant Sci. 2014, 19, 371–379. [Google Scholar] [CrossRef] [PubMed]
- Zandalinas, S.I.; Mittler, R.; Balfagón, D.; Arbona, V.; Gómez-Cadenas, A. Plant adaptations to the combination of drought and high temperatures. Physiol. Plant. 2018, 162, 2–12. [Google Scholar] [CrossRef]
- Ahuja, I.; Vos, R.C.H.D.; Bones, A.M.; Hall, R.D. Plant molecular stress responses face climate change. Trends Plant Sci. 2010, 15, 664–674. [Google Scholar] [CrossRef] [PubMed]
- Osakabe, Y.; Osakabe, K.; Shinozaki, K.; Tran, L.S.P. Response of plants to water stress. Front. Plant Sci. 2014, 5, 86. [Google Scholar] [CrossRef] [PubMed]
- Saibo, N.J.M.; Lourenco, T.; Oliveira, M.M. Transcription factors and regulation of photosynthetic and related metabolism under environmental stresses. Ann. Bot. 2008, 103, 609–623. [Google Scholar] [CrossRef] [PubMed]
- Singh, K.B.; Foley, R.C.; Oñate-Sánchez, L. Transcription factors in plant defense and stress responses. Curr. Opin. Plant Biol. 2002, 5, 430–436. [Google Scholar] [CrossRef]
- Yamaguchi-Shinozaki, K.; Shinozaki, K. Transcriptional regulatory networks in cellular responses and tolerance to dehydration and cold stresses. Annu. Rev. Plant Biol. 2006, 57, 781–803. [Google Scholar] [CrossRef] [PubMed]
- Jiang, J.; Ma, S.; Ye, N.; Jiang, M.; Cao, J.; Zhang, J. WRWY transcription factors in plant responses to stresses. J. Integr. Plant Biol. 2017, 59, 86–101. [Google Scholar] [CrossRef] [PubMed]
- Nuruzzaman, M.; Sharoni, A.M.; Kikuchi, S. Roles of NAC transcription factors in the regulation of biotic and abiotic stress responses in plants. Front. Microbiol. 2013, 4, 248. [Google Scholar] [CrossRef] [PubMed]
- Ambawat, S.; Sharma, P.; Yadav, N.R.; Yadav, R.C. MYB transcription factor genes as regulators for plant responses: An overview. Physiol. Mol. Biol. Plants Int. J. Funct. Plant Biol. 2013, 19, 307–321. [Google Scholar] [CrossRef] [PubMed]
- Mitsuda, N.; Hisabori, T.; Takeyasu, K.; Sato, M.H. VOZ.; Isolation and Characterization of Novel Vascular Plant Transcription Factors with a One-Zinc Finger from Arabidopsis thaliana. Plant Cell Physiol. 2004, 45, 845–854. [Google Scholar] [CrossRef] [PubMed]
- Celesnik, H.; Ali, G.S.; Robison, F.M.; Reddy, A.S.N. Arabidopsis thaliana voz (vascular plant one-zinc finger) transcription factors are required for proper regulation of flowering time. Biol. Open. 2013, 2, 424–431. [Google Scholar] [CrossRef]
- Kumar, S.; Choudhary, P.; Gupta, M.; Nath, U. Vascular plant one-zinc finger1 (voz1) and voz2 interact with constans and promote photoperiodic flowering transition. Plant Physiol. 2018, 176, 2917–2930. [Google Scholar] [CrossRef]
- Prasad, K.V.S.K.; Xing, D.; Reddy, A.S.N. Vascular Plant One-Zinc-Finger (VOZ) Transcription Factors Are Positive Regulators of Salt Tolerance in Arabidopsis. Int. J. Mol. Sci. 2018, 19, 3731. [Google Scholar] [CrossRef]
- Yasui, Y.; Mukougawa, K.; Uemoto, M.; Yokofuji, A.; Suzuri, R.; Nishitani, A.; Kohchi, T. The phytochrome–interacting vascular plant one-zinc finger1 and voz2 redundantly regulate flowering in Arabidopsis. Plant Cell 2012, 24, 3248–3263. [Google Scholar] [CrossRef]
- Nakai, Y.; Fujiwara, S.; Kubo, Y.; Sato, M.H. Overexpression of voz2 confers biotic stress tolerance but decreases abiotic stress resistance in Arabidopsis. Plant Signal. Behav. 2013, 8, e23358. [Google Scholar] [CrossRef]
- Nakai, Y.; Nakahira, Y.; Sumida, H.; Takebayashi, K.; Nagasawa, Y.; Yamasaki, K.; Akiyama, M.; Ohme-Takagi, M.; Fujiwara, S.; Shiina, T.; et al. Vascular plant one-zinc-finger protein 1/2 transcription factors regulate abiotic and biotic stress responses in Arabidopsis. Plant J. 2013, 73, 761–775. [Google Scholar] [CrossRef] [PubMed]
- Selote, D.; Matthiadis, A.; Gillikin, J.W.; Sato, M.H.; Long, T.A. The E3 ligase brutus facilitates degradation of voz1/2 transcription factors. Plant Cell Environ. 2018, 41, 2463–2474. [Google Scholar] [CrossRef] [PubMed]
- Song, C.; Lee, J.; Kim, T.; Hong, J.-C.Z.; Lim, C.O. VOZ1, a transcriptional repressor of DREB2C, mediates heat stress responses in Arabidopsis. Planta 2018, 247, 1439–1448. [Google Scholar] [CrossRef] [PubMed]
- Koguchi, M.; Yamasaki, K.; Hirano, T.; Sato, M.H. Vascular plant one-zinc-finger protein 2 is localized both to the nucleus and stress granules under heat stress in Arabidopsis. Plant Signal. Behav. 2017, 12, e1295907. [Google Scholar] [CrossRef]
- Gao, B.; Chen, M.; Li, X.; Liang, Y.; Zhu, F.; Liu, T.; Zhang, D.; Wood, A.J.; Oliver, M.J.; Zhang, J. Evolution by duplication: Paleopolyploidy events in plants reconstructed by deciphering the evolutionary history of VOZ transcription factors. BMC Plant Biol. 2018, 18, 256. [Google Scholar] [CrossRef] [PubMed]
- Tian, F.; Yang, D.C.; Meng, Y.Q.; Jin, J.; Gao, G. PlantRegMap: Charting functional regulatory maps in plants. Nucleic Acids Res. 2019, 48, D1104–D1113. [Google Scholar] [CrossRef]
- Eisenhaber, F.; Bork, P. Wanted: Subcellular localization of proteins based on sequence. Trends Cell Biol. 1998, 8, 169–170. [Google Scholar] [CrossRef]
- Severin, A.J.; Woody, J.L.; Bolon, Y.T.; Joseph, B.; Diers, B.W.; Farmer, A.D.; Muehlbauer, G.J.; Nelson, R.T.; Grant, D.; Specht, J.E.; et al. RNA-seq atlas of Glycine max: A guide to the soybean transcriptome. BMC Plant Biol. 2010, 10, 160. [Google Scholar] [CrossRef]
- Kereszt, A.; Li, D.X.; Indrasumunar, A.; Nguyen, C.D.T.; Nontachaiyapoom, S.; Kinkema, M.; Gresshoff, P.M. Agrobacterium rhizogenes-mediated transformation of soybean to study root biology. Nat. Protoc. 2007, 2, 948–952. [Google Scholar] [CrossRef]
- Bresson, J.; Varoquaux, F.; Bontpart, T.; Touraine, B.; Vile, D. The PGPR strain Phyllobacterium brassicacearum STM196 induces a reproductive delay and physiological changes that result in improved drought tolerance in Arabidopsis. New Phytol. 2013, 200, 558–569. [Google Scholar] [CrossRef]
- Feng, Z.J.; He, G.H.; Zheng, W.J.; Lu, P.P.; Chen, M.; Gong, Y.M.; Ma, Y.Z.; Xu, Z.S. Foxtail millet NF-Y families: Genome-wide survey and evolution analyses identified two functional genes important in abiotic stresses. Front. Plant Sci. 2015, 6, 1142. [Google Scholar] [CrossRef] [PubMed]
- Mittler, R. Abiotic stress, the field environment and stress combination. Trends Plant Sci. 2006, 11, 15–19. [Google Scholar] [CrossRef] [PubMed]
- Jensen, M.K.; Kjaersgaard, T.; Nielsen, M.M.; Galberg, P.; Petersen, K.; O’Shea, C.; Skriver, K. The Arabidopsis thaliana NAC transcription factor family: Structure-function relationships and determinants of ANAC019 stress signaling. Biochem. J. 2010, 426, 183–196. [Google Scholar] [CrossRef] [PubMed]
- Schmutz, J.; Cannon, S.B.; Schlueter, J.; Ma, J.; Mitros, T.; Nelson, W.; Hyten, D.L.; Song, Q.; Thelen, J.J.; Cheng, J.; et al. Genome sequence of the palaeopolyploid soybean. Nature 2010, 465, 120. [Google Scholar] [CrossRef]
- Fedorova, L.; Fedorov, A. Introns in gene evolution. Genetica 2003, 118, 123–131. [Google Scholar] [CrossRef]
- Le, H.H.; Nott, A.; Moore, M.J. How introns influence and enhance eukaryotic gene expression. Trends Biochem. Sci. 2003, 28, 215–220. [Google Scholar]
- Roy, S.W.; Penny, D. Patterns of intron loss and gain in plants: Intron loss-dominated evolution and genome-wide comparison of O. sativa and A. thaliana. Mol. Biol. Evol. 2007, 24, 171–181. [Google Scholar] [CrossRef]
- Busk, P.K.; Pages, M. Regulation of abscisic acid-induced transcription. Plant Mol. Biol. 1998, 37, 425–435. [Google Scholar] [CrossRef]
- Durrant, W.E.; Dong, X. Systemic acquired resistance. Annu. Rev. Phytopathol. 2004, 42, 185–209. [Google Scholar] [CrossRef]
- Loake, G.; Grant, M. Salicylic acid in plant defence-the players and protagonists. Curr. Opin. Plant Biol. 2007, 10, 466–472. [Google Scholar] [CrossRef]
- Yasuda, M.; Ishikawa, A.; Jikumaru, Y.; Seki, M.; Nakashita, H. Antagonistic interaction between systemic acquired resistance and the abscisic acid-mediated abiotic stress response in Arabidopsis. Plant Cell 2008, 20, 1678–1692. [Google Scholar] [CrossRef] [PubMed]
- Bari, R.; Jones, J.D.G. Role of plant hormones in plant defence responses. Plant Mol. Biol. 2009, 69, 473–488. [Google Scholar] [CrossRef] [PubMed]
- Gamalero, E.; Glick, B.R. Ethylene and Abiotic Stress Tolerance in Plants. In Environmental Adaptations and Stress Tolerance of Plants in the Era of Climate Change; Springer: New York, NY, USA, 2012; pp. 395–412. [Google Scholar]
- Wasternack, C.; Hause, B. Jasmonates: Biosynthesis, perception, signal transduction and action in plant stress response, growth and development. Ann. Bot. 2013, 111, 1021–1058. [Google Scholar] [CrossRef] [PubMed]
- Verma, V.; Ravindran, P.; Kumar, P.P. Plant hormone-mediated regulation of stress responses. BMC Plant Biol. 2016, 16, 86. [Google Scholar] [CrossRef] [PubMed]
- Urao, T.; Yamaguchi-Shinozaki, K.; Urao, S.; Shinozaki, K. An Arabidopsis MYB homolog is induced by dehydration stress and its gene product binds to the conserved MYB recognition sequence. Plant Cell 1993, 5, 1529–1539. [Google Scholar] [PubMed]
- Raventós, D.; Jensen, A.B.; Rask, M.B.; Casacuberta, J.M.; Mundy, J.; San Segundo, B. A 20bp cis-acting element is both necessary and sufficient to mediate elicitor response of a maize PRms gene. Plant J. 1995, 7, 147–155. [Google Scholar] [CrossRef] [PubMed]
- Choi, J.J.; Klosterman, S.J.; Hadwiger, L.A. A promoter from pea gene DRR206 is suitable to regulate and elicitor-coding gene and develop disease resistance. Phytopathology 2004, 94, 651–660. [Google Scholar] [CrossRef]
- Ko, D.K.; Lee, M.O.; Hahn, J.S.; Kim, B.G.; Hong, C.B. Submergence—Inducible and circadian rhythmic basic helix-loop-helix protein gene in Nicotiana tabacum. J. Plant Physiol. 2009, 166, 1090–1100. [Google Scholar] [CrossRef]
- Kovalchuk, N.; Jia, W.; Eini, O.; Morran, S.; Pyvovarenko, T.; Fletcher, S.; Bazanova, N.; Harris, J.; Beck-Oldach, K.; Shavrukov, Y.; et al. Optimization of TaDREB3 gene expression in transgenic barley using cold-inducible promoters. Plant Biotechnol. J. 2013, 11, 659–670. [Google Scholar] [CrossRef]
- Bang, S.W.; Park, S.H.; Jeong, J.S.; Kim, Y.S.; Jung, H.; Ha, S.H.; Kim, J.K. Characterization of the stress-inducible OsNCED3 promoter in different transgenic rice organs and over three homozygous generations. Planta 2013, 237, 211–224. [Google Scholar] [CrossRef]
- Fujita, M.; Fujita, Y.; Noutoshi, Y.; Takahashi, F.; Narusaka, Y.; Yamaguchi-Shinozaki, K.; Shinozaki, K. Crosstalk between abiotic and biotic stress responses: A current view from the points of convergence in the stress signaling networks. Curr. Opin. Plant Biol. 2006, 9, 436–442. [Google Scholar] [CrossRef] [PubMed]
- Mitsuda, N.; Takeyasu, K.; Sato, M.H. Pollen-specific regulation of vacuolar H+-PPase expression by multiple cis–Acting elements. Plant Mol. Biol. 2001, 46, 185–192. [Google Scholar] [CrossRef] [PubMed]
- Zeevaart, J.A.D. Physiology of flower formation. Annu. Rev. Plant Physiol. 1976, 27, 321–348. [Google Scholar] [CrossRef]
- Luo, Q.L.; Li, Y.G.; Gu, H.Q. The promoter of soybean photoreceptor gmplp1 gene enhances gene expression under plant growth regulator and light stresses. Plant Cell Tissue Organ Cult. 2013, 114, 109–119. [Google Scholar] [CrossRef]
- Thompson, J.D.; Gibson, T.J.; Plewniak, F.; Higgins, D.G. The CLUSTAL_X windows interface: Flexible strategies for multiple sequence alignment aided by quality analysis tool. Nucleic Acids Res. 1997, 25, 4876–4882. [Google Scholar] [CrossRef]
- Tamura, K.; Stecher, G.; Peterson, D.; Filipski, A.; Kuma, S. MEGA6: Molecular evolutionary genetics analysis version 6.0. Mol. Biol. Evol. 2013, 30, 2725–2729. [Google Scholar] [CrossRef]
- Hu, B.; Jin, J.P.; Guo, A.Y.; Zhang, H.; Luo, J.-C.Z.; Gao, G. GSDS2.0: An upgraded gene feature visualization server. Bioinformatics 2015, 31, 1296–1297. [Google Scholar] [CrossRef]
- Lescot, M.; Déhais, P.; Thijs, G.; Marchal, K.; Moreau, Y.; Van de Peer, Y.; Rouzé, P.; Rombauts, S.V. PlantCARE, a database of plant cis-acting regulatory elements and a portal to tools for in silico analysis of promoter sequences. Nucleic Acids Res. 2002, 30, 325–327. [Google Scholar] [CrossRef]
- Yoo, S.D.; Cho, Y.H.; Sheen, J. Arabidopsis mesophyll protoplasts: A versatile cell system for transient gene expression analysis. Nat. Protoc. 2007, 2, 1565–1572. [Google Scholar] [CrossRef]
- Fang, Z.W.; Zhang, X.H.; Gao, J.F.; Wang, P.K.; Xu, X.Y.; Liu, Z.X.; Shen, S.H.; Feng, B.L. A buckwheat (Fagopyrum esculentum) DRE–Binding transcription factor gene, FeDREB1, enhances freezing and drought tolerance of transgenic Arabidopsis. Plant Mol. Biol. Rep. 2015, 33, 1510–1525. [Google Scholar] [CrossRef]
- Chen, C.J.; Chen, H.; He, Y.H.; Xia, R. TBtools, a Toolkit for Biologists integrating various biological data handling tools with a user-friendly interface. BioRxiv 2018, 28966. [Google Scholar] [CrossRef]
- Zhang, G.; Chen, M.; Li, L.; Xu, Z.; Chen, X.; Guo, J.; Ma, Y. Overexpression of the soybean GmERF3 gene, an AP2/ERF type transcription factor for increased tolerances to salt, drought, and diseases in transgenic tobacco. J. Exp. Bot. 2009, 60, 3781–3796. [Google Scholar] [CrossRef] [PubMed]
- Livak, K.J.; Schmittgen, T.D. Analysis of relative gene expression data using real-time quantitative PCR and the 2−ΔΔCt method. Methods 2001, 25, 402–408. [Google Scholar] [CrossRef] [PubMed]
- Hu, W.; Huang, C.; Deng, X.; Zhou, S.; Chen, L.; Li, Y.; Wang, C.; Ma, Z.B.; Yuan, Q.Q.; Wang, Y.; et al. TaASR1, a transcription factor gene in wheat, confers drought stress tolerance in transgenic tobacco. Plant Cell Environ. 2013, 36, 1449–1464. [Google Scholar] [CrossRef]
© 2020 by the authors. Licensee MDPI, Basel, Switzerland. This article is an open access article distributed under the terms and conditions of the Creative Commons Attribution (CC BY) license (http://creativecommons.org/licenses/by/4.0/).